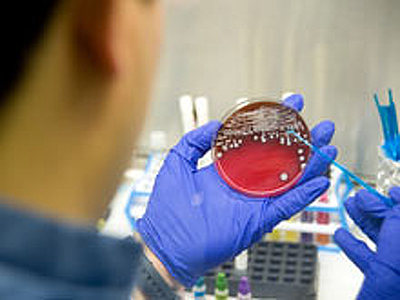

На западе США была задержана вооруженная злоумышленница, которая захватила в заложники топ-менеджера компании, которая занимается производством воздушной кукурузы.
Преступление было совершено в калифорнийском городе Эль-Сегундо во вторник. Полицейским удалось убедить подозреваемую выпустить своего пленника лишь через три с лишним часа телефонных переговоров. Спустя еще полчаса девушка сдалась властям.
В полиции округа Лос-Анджелес сообщают, что молодая женщина, вооруженная пистолетом, вошла в 8:20 в офис компании по производству попкорна Popcornopolis. Угрожая оружием сотрудникам, она велела им убираться из здания вон. После этого девушка под дулом пистолета вывела в отдельный кабинет финансового директора организации. В помещении злоумышленница забаррикадировалась, но позже согласилась вступить в переговоры с полицейскими, прибывшими на место происшествия.
В настоящий момент блюстители закона стараются выяснить мотивы подозреваемой, которой около 20 лет. По предварительным данным, девушка является сотрудницей Popcornopolis.